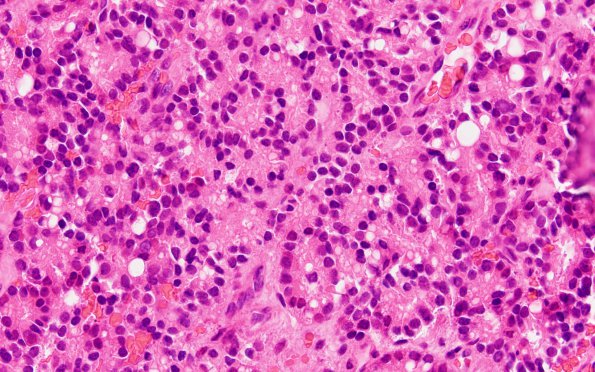
5A2 Metastasis, prostate (Case 5)  H&E 3

Table of Contents
Washington University Experience | NEOPLASMS (METASTASES) | Microscopic | 5A2 Metastasis, prostate (Case 5) H&E 3
Sections show tumor cells arranged in sheets and cribriform architecture involving bone. The tumor cells exhibit predominantly condensed chromatin without prominent nucleoli.